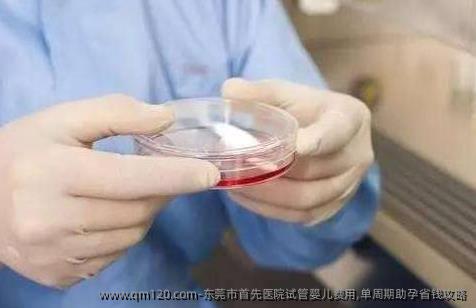

截止2023年初,东莞可开展辅助生殖技术的医院有6家:东莞市人民医院,东莞广济医院,东莞康华医院,东莞东华医院,东莞市松山湖中心医院,东莞市妇幼保健院。
文章数量:602篇
问答数量:112篇
更新于:2025-09-30 23:35:02
标签百科
目录索引
知识
问答摘要
东莞市隶属于广东省,据卫计委公布的“经批准开展人类辅助生殖技术和设置人类**的医疗机构名单”中,东莞市有6家可开展辅助生殖技术的医院,目前能够开展的人工辅助生殖项目有夫**人工授精技术、特需人工授精技术、常规体外受精-胚胎移植技术(第一代试管婴儿技术)、卵胞浆内单精子显微注射技术(第二代试管婴儿技术),所以在辅助生殖这方面的选择区间比较大,在实际的情况的中应该根据自身的情况来进行选择。
| 序号 | 医院名称 | 级别 | 医院地址 |
| 1 | 东莞市人民医院 | 三甲 | 广东省东莞市万江区新谷涌万道路南3号 |
| 2 | 东莞广济医院 | 三乙 | 广东省东莞市凤岗镇雁田镇田北路1号 |
| 3 | 东莞康华医院 | 三乙 | 广东省东莞市东莞大道1000号 |
| 4 | 东莞东华医院 | 三甲 | 广东省东莞市东城区东城东路1号 |
| 5 | 东莞市松山湖中心医院 | 三甲 | 广东省东莞市石龙镇黄州区祥龙路1号 |
| 6 | 东莞市妇幼保健院 | 三甲 | 广东省东莞市东城区振兴路99号 |
| 医院名称 | 三代费用 | 二代费用 | 一代费用 | **人工授精 | 特需人工授精 |
| 东莞市人民医院 | 暂无此技术 | 4-5万元左右 | 3-5万元左右 | 2万元左右 | 暂无此技术 |
| 东莞广济医院 | 暂无此技术 | 3-6万元左右 | 3-5万元左右 | 1.5万元左右 | 暂无此技术 |
| 东莞康华医院 | 暂无此技术 | 3-6万元左右 | 3-5万元左右 | 1-3万元左右 | 暂无此技术 |
| 东莞东华医院 | 暂无此技术 | 4-6万元左右 | 3-5万元左右 | 1万元左右 | 暂无此技术 |
| 东莞市松山湖中心医院 | 暂无此技术 | 4-7万元左右 | 3-5万元左右 | 15000元左右 | 暂无此技术 |
| 东莞市妇幼保健院 | 暂无此技术 | 4-6万元左右 | 3-5万元左右 | 2万元左右 | 暂无此技术 |
注:数据来源网络,具体费用依当地医院为准。
| 医院名称 | 三代成功率 | 二代成功率 | 一代成功率 | **人工授精 | 特需人工授精 |
| 东莞市人民医院 | 暂无此技术 | 50%左右 | 33%左右 | 25%左右 | 暂无此技术 |
| 东莞广济医院 | 暂无此技术 | 50%左右 | 40%左右 | 20%左右 | 暂无此技术 |
| 东莞康华医院 | 暂无此技术 | 50%左右 | 35%左右 | 20%左右 | 暂无此技术 |
| 东莞东华医院 | 暂无此技术 | 48%-50%左右 | 35%-42%左右 | 30%左右 | 暂无此技术 |
| 东莞市松山湖中心医院 | 暂无此技术 | 45-50%左右 | 35%-42%左右 | 28%左右 | 暂无此技术 |
| 东莞市妇幼保健院 | 暂无此技术 | 55%左右 | 36%左右 | 28%左右 | 暂无此技术 |
注:数据来源网络,具体成功率依当地医院为准。
东莞比较好的试管婴儿医院有:东莞市人民医院,东莞东华医院,东莞市松山湖中心医院,东莞市妇幼保健院,东莞广济医院,东莞康华医院
为方便查询各省及直辖市可开展试管婴儿的医院,可点击下方链接进入相应的机构列表页面,获取医院的相关信息:
| 国内地区导航 | ||||
| 上海 | 北京 | 江苏 | 广东 | 陕西 |
| 河南 | 天津 | 海南 | 浙江 | 重庆 |
| 辽宁 | 湖北 | 四川 | 山东 | 河北 |
| 贵州 | 内蒙古 | 福建 | 甘肃 | 山西 |
| 湖南 | 吉林 | 安徽 | 广西 | 新疆 |
| 云南 | 宁夏 | 黑龙江 | 江西 | 青海 |
| 西藏 | 香港 | 澳门 | 台湾 | |
东莞试管婴儿医院
查看更多
东莞试管婴儿费用
查看更多
东莞试管婴儿成功率
查看更多
东莞试管婴儿哪家好
查看更多
东莞试管婴儿报销**
查看更多
东莞试管婴儿多少钱
查看更多

2025年东莞市可以做试管婴儿的医院有哪些?费用纳入医保了吗?
2025年东莞市可以做试管婴儿的医院有哪些?费用纳入医保了吗?开展人类辅助生殖技术的医疗机构医院名称医院地址医院性质东莞东华医院广东省东莞市东城区东城东路1号公立医院东莞康华医院广东省东莞市东莞大道1
2025-09-30 23:35:02 · 5次浏览

东莞私立机构试管婴儿费用贵吗,费用构成一览
在东莞,不少家庭因为生育问题会考虑做试管婴儿。如果选择去私立机构,很多人最关心的就是费用问题。那到底贵不贵呢?其实这个要看具体情况,不同机构、不同治疗方案,价格也会有差别。开展人类辅助生殖技术的医疗机
2025-09-22 09:24:49 · 5次浏览

东莞做试管婴儿医院哪家比较好?3招找到靠谱助孕机构
在东莞,很多夫妻因为各种原因会选择做试管婴儿,但面对市面上五花八门的助孕机构和医院,很多人不知道该怎么选。今天就来聊聊,怎么找到靠谱的试管婴儿机构,帮你少走弯路。开展人类辅助生殖技术的医疗机构医院名称
2025-09-21 04:24:36 · 5次浏览

东莞三代试管婴儿要准备多少钱?让你知道要花多少钱?
在东莞做三代试管婴儿,很多夫妻最关心的就是费用问题。说实话,这个过程确实不便宜,但具体要花多少钱,还是要根据每个人的身体情况、医院**、用药方案来定。东莞三代试管婴儿费用东莞地区三代试管的费用在6-1
2025-09-15 17:20:49 · 5次浏览

东莞康华医院试管生育费用明细,预算规划新指南
很多朋友在考虑做试管婴儿的时候,最关心的问题之一就是费用到底要花多少钱。如果你也在东莞,考虑去东莞康华医院做试管,那这篇文章就来跟你说说大概的费用情况,帮你提前做好预算准备,心里有个底。开展人类辅助生
2025-09-07 07:00:52 · 5次浏览
东莞市首先医院试管婴儿费用,单周期助孕省钱攻略
在东莞,想要通过试管婴儿技术来助孕的夫妻越来越多,而大家最关心的问题之一就是费用。今天我们就来聊聊东莞市首先医院的试管婴儿费用情况,顺便分享一些单周期助孕省钱的小攻略,希望能帮到有需要的朋友。开展人类
2025-09-05 16:40:54 · 5次浏览

东莞私立机构睾丸穿刺试管的成功率多高,成功率数据参考
东莞的私立医疗机构在男科领域,尤其是像睾丸穿刺取精结合试管婴儿这样的技术上,确实有提供相关服务。不过,成功率这种事儿,得看很多因素,不能一概而论。开展人类辅助生殖技术的医疗机构医院名称医院地址医院级别
2025-08-29 06:00:04 · 5次浏览

东莞私立机构试管初次成功率有多高,成功率数据参考
在东莞,有不少私立机构提供试管婴儿服务,很多人关心的问题就是:做一次试管的成功率到底有多高?其实这个问题没有一个固定答案,因为成功率会受到很多因素的影响,比如年龄、身体状况、医生的技术水平,以及医院的
2025-08-29 05:39:50 · 5次浏览

东莞私立医院试管第三代技术怎么样,成功率与优势分析
在东莞,有不少人会考虑去私立医院做试管婴儿,尤其是第三代试管技术。这项技术比起前两代来说,确实有一些新的优势,但大家最关心的还是成功率、费用以及整个过程的体验。下面我们就来聊聊东莞这边私立医院做第三代
2025-08-28 08:39:56 · 5次浏览

东莞私立机构3代试管成功率有多高,如何提高成功机率
东莞作为广东省的一个重要城市,近年来在医疗技术方面发展迅速,不少私立医疗机构也陆续开展了第三代试管婴儿技术。很多人关心的是,这种技术的成功率到底有多高,以及自己能做些什么来提高成功率。开展人类辅助生殖
2025-08-28 07:19:45 · 5次浏览

东莞私立第三代试管婴儿好医院有哪些,成功率高吗
在东莞,有不少人对试管婴儿技术感兴趣,尤其是第三代试管婴儿,因为它可以帮助筛查胚胎的染色体,提高成功率,降低遗传病风险。如果你是想了解东莞有没有靠谱的私立医院做第三代试管婴儿,以及成功率高不高的问题,
2025-08-28 04:59:40 · 5次浏览

东莞私立机构宫腔粘连做试管成功率如何,内附调理方法与注意事项
在东莞,一些私立医疗机构也提供试管婴儿服务,其中包括针对宫腔粘连问题的辅助生殖治疗。宫腔粘连是女性不孕的常见原因之一,很多姐妹在尝试自然受孕失败后,会选择试管婴儿这条路。那到底成功率如何?调理方法和注
2025-08-27 05:19:44 · 5次浏览

东莞私立机构试管婴儿第三代成功率高吗,影响因素有哪些
在东莞,有不少私立机构提供试管婴儿服务,其中也包括第三代试管婴儿技术。很多人关心的是,这种技术的成功率到底高不高,以及有哪些因素会影响成功率。下面我们就来聊一聊这个话题,尽量用通俗易懂的方式来说清楚。
2025-08-26 12:21:52 · 5次浏览

东莞私立机构试管成功率对比,哪家更可靠,成功率更高些?
在东莞,越来越多的人因为生育问题开始关注试管婴儿这项技术。而除了公立医院,也有不少人会考虑去私立机构做试管,毕竟私立机构服务更灵活、流程更贴心。但问题来了,东莞这么多私立机构,到底哪家成功率更高?哪家
2025-08-25 22:40:45 · 5次浏览

东莞私立试管医院成功率排名,哪家更值得信赖
说到做试管婴儿,很多人会想到去东莞找私立试管医院。毕竟大城市的医疗资源相对集中,选择也多。但问题来了,这么多医院,到底哪家靠谱?成功率高不高?今天咱们就聊聊这个话题,尽量用大白话,不整那些专业术语和官
2025-08-23 20:08:59 · 5次浏览

东莞私立试管婴儿第三代成功率高吗,优秀数据揭晓
在东莞,越来越多的家庭开始关注“私立医院做第三代试管婴儿成功率到底高不高”这个问题。毕竟,试管婴儿技术发展到现在,已经帮助了很多不孕不育的夫妻圆了当父母的梦想。而第三代试管婴儿技术,因为可以筛查胚胎的
2025-08-22 04:39:53 · 5次浏览
东莞康华试管婴儿费用多少?一次会很贵吗
东莞康华试管婴儿费用多少?一次会很贵吗
2025-05-19 09:23:34 · 5次浏览
东莞第三代试管多少费用?费用十万够吗?
东莞第三代试管多少费用?费用十万够吗?
2025-05-13 07:41:30 · 5次浏览
试管婴儿排名揭晓东莞三代试管费用多少钱?
试管婴儿排名揭晓东莞三代试管费用多少钱?
2025-05-13 07:06:47 · 5次浏览
东莞康华医院做试管婴儿费用需要多少钱?5万够吗?
东莞康华医院做试管婴儿费用需要多少钱?5万够吗?
2025-05-11 20:10:54 · 5次浏览
东莞东华医院和东莞妇幼试管哪家强?附详细成功率费用?
东莞东华医院和东莞妇幼试管哪家强?附详细成功率费用?
2025-05-11 15:49:39 · 5次浏览
东莞市试管婴儿生孩子通常要花多少钱?有推荐的医院吗?
东莞市试管婴儿生孩子通常要花多少钱?有推荐的医院吗?
2025-02-28 12:26:14 · 5次浏览
东莞东华医院和东莞妇幼试管哪家强?附详细成功率费用?
东莞东华医院和东莞妇幼试管哪家强?附详细成功率费用?
2025-02-18 17:13:31 · 5次浏览
东莞三代试管排名前五的医院有哪些?附详细成功率费用
东莞三代试管排名前五的医院有哪些?附详细成功率费用
2025-02-15 10:32:20 · 5次浏览
东莞三代试管成功率?
东莞三代试管成功率?
2025-02-15 04:31:53 · 5次浏览
东莞三代试管婴儿需要多少钱?
东莞三代试管婴儿需要多少钱?
2025-02-14 23:39:43 · 5次浏览
东莞大人小孩做试管成功率高吗?
东莞大人小孩做试管成功率高吗?
2025-02-14 04:11:11 · 5次浏览
东莞第三代试管婴儿大约多少钱?
东莞第三代试管婴儿大约多少钱?
2025-01-30 19:48:15 · 5次浏览
东莞做第三代试管婴儿多少钱?
东莞做第三代试管婴儿多少钱?
2025-01-14 07:19:04 · 5次浏览
在东莞做试管婴儿费用是多少?
在东莞做试管婴儿费用是多少?
2025-01-14 06:26:22 · 5次浏览
在东莞做试管婴儿费用是多少?
在东莞做试管婴儿费用是多少?
2025-01-14 06:17:05 · 5次浏览
在东莞做三代试管婴儿多少钱?
在东莞做三代试管婴儿多少钱?
2025-01-14 05:57:34 · 5次浏览
正在热议
城市
文章
标签
声明:本站信息仅供参考不能作为诊断及医疗的依据 如有转载或引用文章涉及版权问题请速与我们联系
Copyright© 2003-2025 All Rights Reserved 版权所有 网址导航
扫码查看手机版